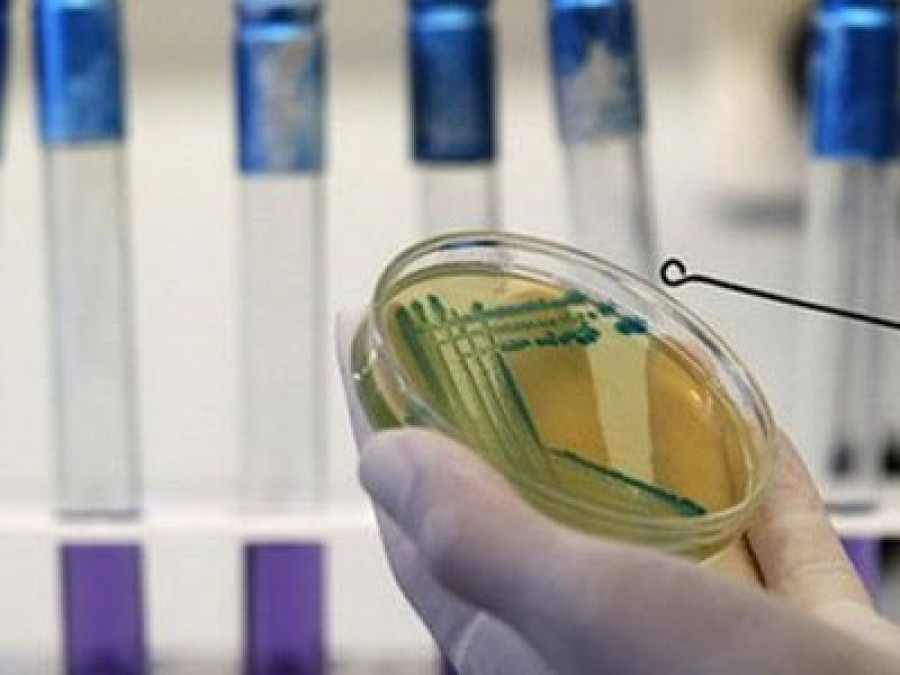
U BiH virus afričke svinjske kuge potvrđen na 560 imanja, eutanazirane 28.784 svinje

U BiH virus afričke svinjske kuge potvrđen na 560 imanja, eutanazirane 28.784 svinje
U Bosni i Hercegovini virus afričke svinjske potvrđen je virus afričke svinjske kuge na 560 imanja, dok su eutanazirane 28.784 svinje.
U Republici Srpskoj virus je potvrđen na 463 imanja, a eutanazirano je 26.788 svinja. U Federaciji BiH virus je potvrđen na 30 imanja, a eutanazirano je 196 svinja dok je u Brčko Distriktu zaraženo 67 imanja, a eutanazirano 1800 svinja, rečeno je Feni iz Ureda za veterinatrstvo u okviru Ministarstva vanjske trgovine i ekonomskih odnosa, vezano za epidemiološku situaciju po pitanju afričke svinjske kuge u BiH zaključno sa sedmim augustom.
Ističu da Ured za veterinarstvo BiH kontinuirano radi na iznalaženju donatorskih sredstava koji mogu pomoći u borbi protiv afričke svinjske kuge.
- Preko Austrijske agencije za zdravlje i sigurnost hrane (AGES) osigurana je pomoć od više paleta laboratorijske opreme, a u toku su pregovori i sa Ambasadom Kine u BiH oko nabavke dodatne opreme. Ured je prethodno uputio zahtjev za pomoć i Svjetskoj organizaciji za zdravlje životinja (WOAH), Organizaciji za prehranu i poljoprivredu Ujedinjenih nacija (FAO) i Evropskoj komisiji - navode iz Ureda za veterinarstvo.
federalna.ba/Fena